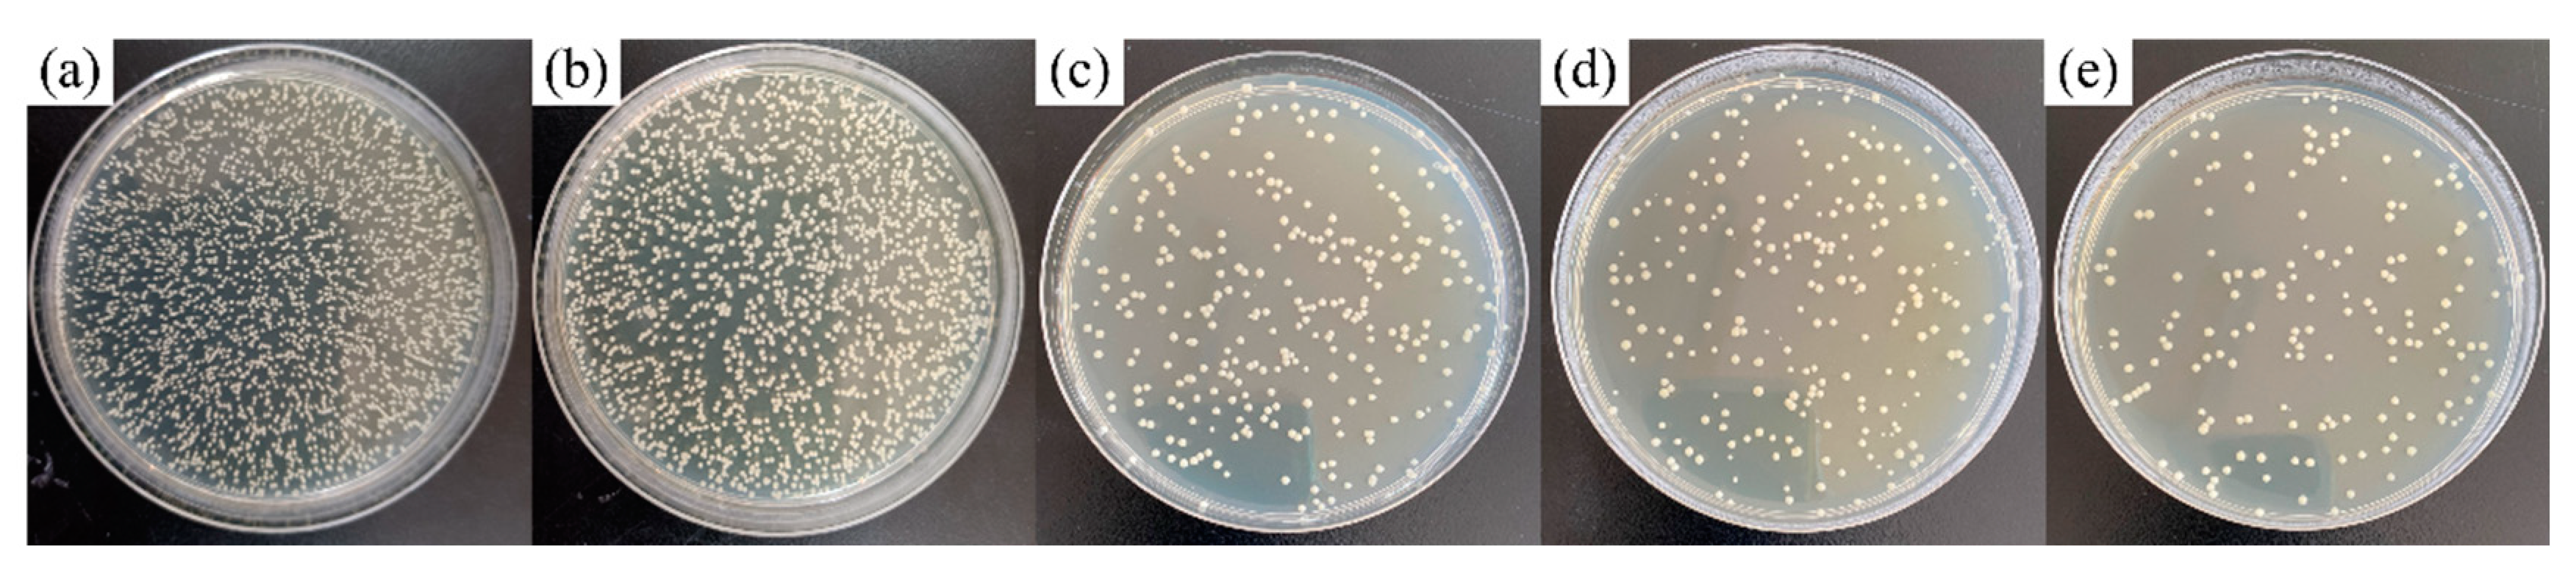
Coatings 11 01213 g010
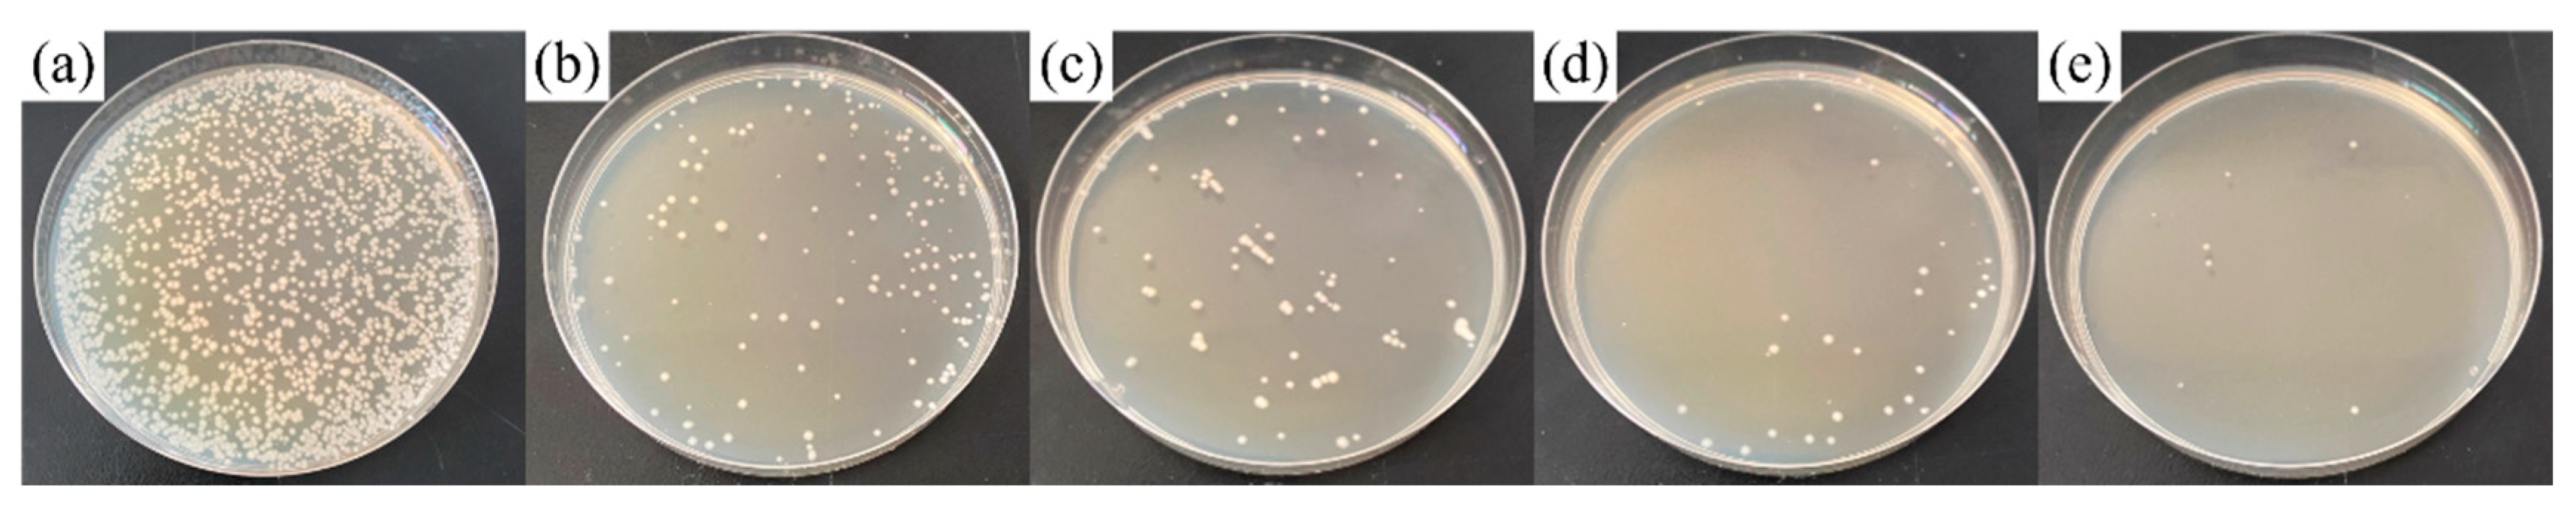
Coatings 11 01213 g011

Microstructure, Mechanical and Antibacterial Properties of TiNb-Based Alloy Implanted by Silver Ions
Abstract
:1. Introduction
2. Materials and Methods
2.1. Modification of Specimens
2.2. Surface Characterization
2.3. Mechanical Properties Tests
2.4. In Vitro Antibacterial Evaluation
3. Results
3.1. Characterization of Ag-Implanted Layer
3.2. Mechanical Properties
3.3. Antibacterial Performance
4. Conclusions
Author Contributions
Funding
Institutional Review Board Statement
Informed Consent Statement
Data Availability Statement
Conflicts of Interest
References
- Geetha, M.; Singh, A.K.; Asokamani, R.; Gogia, A.K. Ti based biomaterials, the ultimate choice for orthopaedic implants-A review. Prog. Mater. Sci. 2009, 54, 397–425. [Google Scholar] [CrossRef]
- Niinomi, M. Mechanical biocompatibilities of titanium alloys for biomedical applications. J. Mech. Behav. Biomed. Mater. 2008, 1, 30–42. [Google Scholar] [CrossRef]
- Long, M.; Rack, H.J. Titanium alloys in total joint replacement-a materials science perspective. Biomaterials 1998, 19, 1621–1639. [Google Scholar] [CrossRef]
- Gepreel, M.A.H.; Niinomi, M. Biocompatibility of Ti-alloys for long-term implantation. J. Mech. Behav. Biomed. Mater. 2013, 20, 407–415. [Google Scholar] [CrossRef]
- Niinomi, M.; Hattori, T.; Morikawa, K.; Kasuga, T.; Suzuki, A.; Fukui, H.; Niwa, S. Development of low rigidity beta-type titanium alloy for biomedical applications. Mater. Trans. 2002, 43, 2970–2977. [Google Scholar] [CrossRef] [Green Version]
- Hao, Y.L.; Yang, R.; Niinomi, M.; Kuroda, D.; Zhou, Y.L.; Fukunaga, K.; Suzuki, A. Aging response of the Young’s modulus and mechanical properties of Ti-29Nb-13Ta-4.6Zr for biomedical applications. Metall. Mater. Trans. A 2003, 34, 1007–1012. [Google Scholar] [CrossRef]
- Costerton, J.W.; Stewart, P.S.; Greenberg, E.P. Bacterial biofilms: A common cause of persistent infections. Science 1999, 284, 1318–1322. [Google Scholar] [CrossRef] [PubMed] [Green Version]
- Neoh, K.G.; Hu, X.F.; Zheng, D.; Kang, E.T. Balancing osteoblast functions and bacterial adhesion on functionalized titanium surfaces. Biomaterials 2012, 33, 2813–2822. [Google Scholar] [CrossRef] [PubMed]
- Monteiro, D.R.; Gorup, L.F.; Takamiya, A.S.; Ruvollo-Filho, A.C.; Camargo, E.R.D.; Barbosa, D.B. The growing importance of materials that prevent microbial adhesion: Antimicrobial effect of medical devices containing silver. Int. J. Antimicrob. Agents 2009, 34, 103–110. [Google Scholar] [CrossRef] [PubMed]
- Eckhardt, S.; Brunetto, P.S.; Gagnon, J.; Priebe, M.; Giese, B.; Fromm, K.M. Nanobio silver: Its interactions with peptides and bacteria, and its uses in medicine. Chem. Rev. 2013, 113, 4708–4754. [Google Scholar] [CrossRef] [Green Version]
- Marambio-Jones, C.; Hoek, E.M.V. A review of the antibacterial effects of silver nanomaterials and potential implications for human health and the environment. J. Nanopart. Res. 2010, 12, 1531–1551. [Google Scholar] [CrossRef]
- Gunawan, C.; Teoh, W.Y.; Marquis, C.P.; Lifia, J.; Amal, R. Reversible antimicrobial photoswitching in nanosilver. Small 2009, 5, 341–344. [Google Scholar] [CrossRef] [PubMed]
- Hu, G.S.; Jin, W.X.; Chen, Q.Y.; Cai, Y.C.; Zhu, Q.H.; Zhang, W.Z. Antibacterial activity of silver nanoparticles with different morphologies as well as their possible antibacterial mechanism. Appl. Phys. A Mater. Sci. Process. 2016, 122, 874. [Google Scholar] [CrossRef]
- Qin, Y.; Cheng, L.; Li, R.Y.; Liu, G.C.; Zhang, Y.B.; Tang, X.F.; Wang, J.C.; Liu, H.; Qin, Y.G. Potential antibacterial mechanism of silver nanoparticles and the optimization of orthopedic implants by advanced modification technologies. Int. J. Nanomed. 2018, 13, 3311–3327. [Google Scholar]
- Damm, C.; Munstedt, H. Kinetic aspects of the silver ion release from antimicrobial polyamide/silver nanocomposites. Appl. Phys. A 2008, 91, 479–486. [Google Scholar] [CrossRef]
- Neal, A.L. What can be inferred from bacterium-nanoparticle interactions about the potential consequences of environmental exposure to nanoparticles? Ecotoxicology 2008, 17, 362–371. [Google Scholar] [CrossRef] [PubMed]
- Zhang, X.F.; Shen, W.; Gurunathan, S. Silver nanoparticle-mediated cellular responses in various cell lines: An in vitro model. Int. J. Mol. Sci. 2016, 17, 1603. [Google Scholar] [CrossRef] [Green Version]
- Ahamed, M.; Karns, M.; Goodson, M.; Rowe, J.; Hussain, S.M.; Schlager, J.J.; Hong, Y.L. DNA damage response to different surface chemistry of silver nanoparticles in mammalian cells. Toxicol. Appl. Pharmacol. 2008, 233, 404–410. [Google Scholar] [CrossRef] [PubMed]
- Zhao, L.Z.; Chu, P.K.; Zhang, Y.M.; Wu, Z.F. Antibacterial coatings on titanium implants. J. Biomed. Mater. Res. Part B 2009, 91, 470–480. [Google Scholar] [CrossRef]
- Cao, H.L.; Liu, X.Y.; Meng, F.H.; Chu, P.K. Biological actions of silver nanoparticles embedded in titanium controlled by micro-galvanic effects. Biomaterials 2011, 32, 693–705. [Google Scholar] [CrossRef]
- Qiao, S.; Cao, H.; Zhao, X.; Lo, H.; Zhuang, L.; Gu, Y.; Shi, J.; Liu, X.; Lai, H. Ag-plasma modification enhances bone apposition around titanium dental implants: An animal study in Labrador dogs. Int. J. Nanomed. 2015, 10, 653–664. [Google Scholar]
- Wan, Y.Z.; Raman, S.; He, F.; Huang, Y. Surface modification of medical metals by ion implantation of silver and copper. Vacuum 2007, 81, 1114–1118. [Google Scholar] [CrossRef]
- Cao, H.L.; Tang, K.W.; Liu, X.Y. Bifunctional galvanics mediated selective toxicity on titanium. Mater. Horiz. 2018, 5, 264–267. [Google Scholar] [CrossRef]
- Kumar, N.; Kataria, S.; Dash, S.; Srivastava, S.K.; Das, C.R.; Chandramohan, P.; Tyagi, A.K.; Nair, K.G.M.; Raj, B. Tribological properties of nitrogen ion implanted steel. Wear 2012, 274–275, 60–67. [Google Scholar] [CrossRef]
- Wang, H.W.; Yang, D.Z.; Shi, W.D.; Patu, S. High cycle fatigue life improvement of polycrystalline alpha-iron modified by silver, chromium, aluminium, and yttrium ion implantation. Scr. Metall. Mater. 1995, 32, 2001–2007. [Google Scholar] [CrossRef]
- Pouilleau, J.; Devilliers, D.; Garrido, F.; Durand-Vidal, S.; Mahe, E. Structure and composition of passive titanium oxide films. Mater. Sci. Eng. B 1997, 47, 235–243. [Google Scholar] [CrossRef]
- Battiato, A.; Lorusso, M.; Bernardi, E.; Picollo, F.; Bosia, F.; Ugues, D.; Zelferino, A.; Damin, A.; Baima, J.; Pugno, N.M.; et al. Softening the ultra-stiff: Controlled variation of Young’s modulus in single-crystal diamond by ion implantation. Acta Mater. 2016, 116, 95–103. [Google Scholar] [CrossRef] [Green Version]
- Liu, Y.; Zheng, Z.; Zara, J.N.; Hsu, C.; Soofer, D.E.; Lee, K.S.; Siu, R.K.; Miller, L.S.; Zhang, X.L.; Carpenter, D.; et al. The antimicrobial and osteoinductive properties of silver nanoparticle/poly (DL-lactic-co-glycolic acid)-coated stainless steel. Biomaterials 2012, 33, 8745–8756. [Google Scholar] [CrossRef] [PubMed]
- Wang, M.L.; Cao, H.L.; Meng, F.H.; Zhao, X.B.; Ping, Y.X.; Lu, X.Y.; Liu, X.Y. Schottky barrier dependent antimicrobial efficacy of silver nanoparticles. Mater. Lett. 2016, 179, 1–4. [Google Scholar] [CrossRef]

Publisher’s Note: MDPI stays neutral with regard to jurisdictional claims in published maps and institutional affiliations. |
© 2021 by the authors. Licensee MDPI, Basel, Switzerland. This article is an open access article distributed under the terms and conditions of the Creative Commons Attribution (CC BY) license (https://creativecommons.org/licenses/by/4.0/).
Share and Cite
Tian, T.; Dang, B.; Li, F.; Yang, K.; Wei, D.; Zhang, P. Microstructure, Mechanical and Antibacterial Properties of TiNb-Based Alloy Implanted by Silver Ions. Coatings 2021, 11, 1213. https://doi.org/10.3390/coatings11101213
Tian T, Dang B, Li F, Yang K, Wei D, Zhang P. Microstructure, Mechanical and Antibacterial Properties of TiNb-Based Alloy Implanted by Silver Ions. Coatings. 2021; 11(10):1213. https://doi.org/10.3390/coatings11101213
Chicago/Turabian StyleTian, Tian, Bo Dang, Fengkun Li, Kai Yang, Dongbo Wei, and Pingze Zhang. 2021. "Microstructure, Mechanical and Antibacterial Properties of TiNb-Based Alloy Implanted by Silver Ions" Coatings 11, no. 10: 1213. https://doi.org/10.3390/coatings11101213
APA StyleTian, T., Dang, B., Li, F., Yang, K., Wei, D., & Zhang, P. (2021). Microstructure, Mechanical and Antibacterial Properties of TiNb-Based Alloy Implanted by Silver Ions. Coatings, 11(10), 1213. https://doi.org/10.3390/coatings11101213





